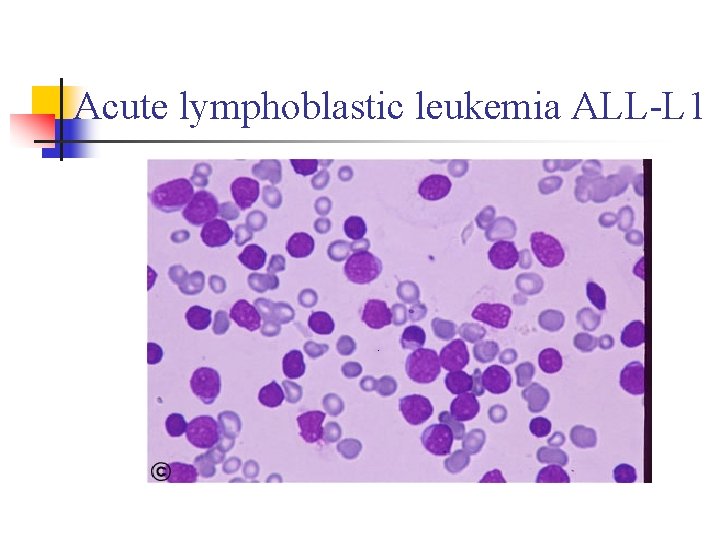
Acute lymphoblastic leukemia ALL-L 1
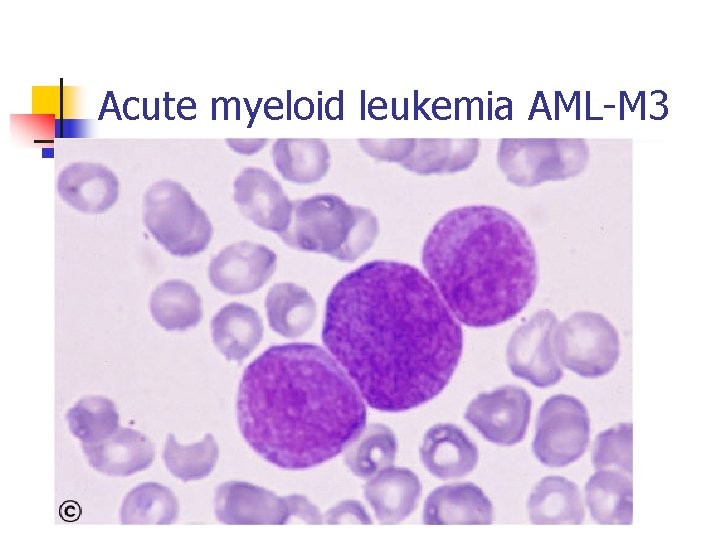
Acute myeloid leukemia AML-M 3
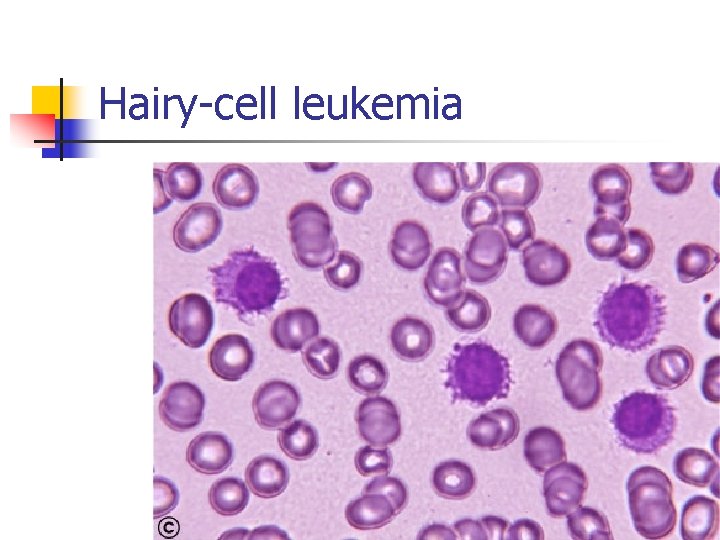
Hairy-cell leukemia

Leukemias The development of Leukemia uncontrolled and accelerated

- Slides: 63
Leukemias The development of Leukemia uncontrolled and accelerated production of haematopoietic stem cell, progenitors, or mature blood cells which results in incomplete or defective cell maturation Acute Lymphocytic Leukemia (ALL) Acute Mylogenous Leukemia (AML) Chronic Lymphocytic Leukemia (CLL) Chronic Mylogenous Leukemia (CML) Copyright, 1996 © Dale Carnegie & Associates, Inc.
Demographics of Leukemia Patients CLL=Chronic Lymphocytic ALL=Acute Lymphocytic CML=Chronic Mylogenous AML=Acute Mylogenous
Stem cells and growth factors in haematopoietic cell development. n page 1003
Hematopoietic stem cells give rise to two major progenitor cell lineages, myeloid and lymphoid progenitors
ALL CLL Lymphomas MM naïv e B-lymphocytes Lymphoid progenitor AML Hematopoietic stem cell Myeloid progenitor Plasma cells T-lymphocytes Myeloproliferative disorders Neutrophils Eosinophils Basophils Monocytes Platelets Red cells
Acute leukemia is characterized by a rapid increase in the numbers of immature blood cells. Crowding due to such cells makes the bone marrow unable to produce healthy blood cells. Immediate treatment is required in acute leukemia due to the rapid progression and accumulation of the malignant cells, which then spill over into the bloodstream and spread to other organs of the body. Acute forms of leukemia are the most common forms of leukemia in children. n
Chronic leukemia n is characterized by the excessive build up of relatively mature, but still abnormal, white blood cells. Typically taking months or years to progress, the cells are produced at a much higher rate than normal cells, resulting in many abnormal white blood cells in the blood. Whereas acute leukemia must be treated immediately, chronic forms are sometimes monitored for some time before treatment to ensure maximum effectiveness of therapy. Chronic leukemia mostly occurs in older people, but can theoretically occur in any age group.
Main Signs and symptoms n 1. Hyperplasia or hyperproliferation of affected cell - uncontrolled proliferation of malignant cells and their spreading (in bone marrow, peripheral blood and organ infiltration (spleen (nausea or feeling of fullness due to an enlarged liver and spleen), lymph nodes, skin, gastrointestinal tract, central nervous system (neurological symptoms (headaches)).
Main Signs and symptom n n 2. Malignant cells replace normal bone marrow elements leading to a) anemia (clinical manifestation - dyspnea and pallor), b) thrombocytopenia (people with leukemia may easily become bruised, bleed excessively, or develop pinprick bleeds (petechiae), c) neutropenia (clinical manifestation - frequent infection, ranging from infected tonsils, sores in the mouth, or diarrhea to life-threatening pneumonia or opportunistic infections),
Main Signs and symptom n n 3. Nonspecific symptoms of intoxication (feeling sick, such as having fevers, chills, night sweats and other flu-like symptoms, or feeling fatigued), 4. Metabolic and Electrolyte Abnormalities
Pictures Of Blood Platelet White Cell Red Cell Blasts Red Cell Normal human blood Blood with leukemia
Development of Leukemia in the Bloodstream Stage 1 - Normal Stage 2 - Symptoms Stage 3 - Diagnosis Legend White Cell Red Cell Platelet Blast Germ Stage 5 a- Anemia Stage 4 - Worsening Stage 5 b- Infection Sources from Leukemia, by D. Newton and D. Siegel
DEFINITION Acute leukemias are clonal malignant hematopoietic disorders resulting from genetic alterations in normal hematopoietic stem cells. These alterations disrupt normal differentiation and/or cause excessive proliferation of abnormal immature “leukemic” cells or “blasts. ” As the disease progresses, leukemic cells accumulate in the bone marrow, blood, and organs, displacing normal progenitor cells and suppressing normal hematopoiesis.
n n Clinical presentation Common symptoms of both acute myeloid leukemia (AML) and acute lymphoblastic leukemia (ALL) are a reflection of bone marrow failure and include fatigue, bruising or bleeding, fever, and infection. n Pancytopenia: n n WBC infection. Hb anemia. platelets bleeding. Organ infiltration: n n Lymphadenopathy. Splenomegally. Hepatomegally. CNS: 5 -10% of patient with ALL
Investigations: n n n CBC: n 60% of pts have an elevated WBC. n Most are anemic n Most are thrombocytopenic n 90% have blast in the periphral blood film. electrolytes: n Hypo/hyper kalemia n Hypomagnesimia n hyperphosphatemia Hypermetabolism: n LDH. n uric acid. DIC: n Most common with promyelocytic leukemia, small% monocytic leukemia & ALL Bone marrow biopsy and aspirate: n 30%or more of all nucleated cells are blast. Radiology: n CXR: mediastinal mass(T-cell ALL) n Osteopenia or lytic lesion 50% of patients with ALL. (itractable pain).
Acute leukemia diagnostic algorithm.
Lymphoblast/myeloblast
Acute lymphoblastic leukemia ALL-L 1
Acute lymphoblastic leukemia ALL-L 1
Acute lymphocytic leukemia ALL-L 2
Acute lymphocytic leukemia ALLL 3
Acute lymphocytic leukemia ALLL 3
Acute myeloid leukemia AML-M 0
Acute myeloid leukemia AML-M 1
Acute myeloid leukemia AML-M 2
Acute myeloid leukemia AML-M 2 + peroxidase
Acute myeloid leukemia AML-M 3
Acute myeloid leukemia AML-M 3 hypogranular
Acute myeloid leukemia AML-M 4
Acute myeloid leukemia AML-M 5
Acute myeloid leukemia AML-M 6
Acute myeloid leukemia AML-M 7
Management: n A-Supportive measure: -isolation in positive laminer flux room -insertion of central line -family and patient support by permanent social worker -Al. Kaline diuresis to prevent tumor lysis syndrome -oropharynx/GIT decontamination to prevent fungal infection -IV antibiotics for infection -Blood transfusion if anemia and thrombocytopenia.
Cont: n Special consideration: CNS: by intrathecal chemotherapy, high dose systemic MTX or Aracytine. OR cerebrospinal irradiation -neuroprophylaxis: - meningeal infiltration : Testis: or chidectomy/radiotherapy if testis involvement.
Prognosis in ALL parameters Good poor WBC low High(>50 x 10 9 /l) Gender Girls Boys Immunophenotype C-ALL B-ALL Age Child Adult or infant. Cytogenetic Normal, hyperdiploid, Ph+, 11 q 23 rearrangements. Time to clear blast from blood < 1 week >1 week Time to remission <4 weeks >4 weeks Cns disease at presentation Absent Present Minimal residual disease. Negative at 1 -3 months Still positive at 3 -6 months.
Prognosis in AML parameters Cytogentics BM response to remission induction age Favorable unfavorable T(15; 17). T(8; 21). Inv(16). Deletion of chromosome 5 or 7. 11 q 23 T(6; 9) Abn(3 q)complex rearrangments <5% blasts after first course >20% blasts after first course. <60 yrs >60 yrs
Chronic lymphocytic leukemia (1) n n n Is characterised by the accumulation of nonproliferating mature-appearing lymphocytes in the blood, marrow, lymph nodes, and spleen In most cases, the cells are monoclonal B lymphocytes that are CD 5+ T cell CLL can occur rarely
CLINICAL Localized or generalized lymphadenopathy n Splenomegaly (30 -40% of cases) n. Hepatomegaly (20% of cases) n Petechiae n. Pallor n
lymphadenopathy
Chronic lymphocytic leukemia
Hairy-cell leukemia
Smudge Cells
Smudge Cells
The diagnostic criteria for CLL 1) A peripheral blood lymphocyte count of greater than 5 G/L, with less than 55% of the cells being atypical 2) The cell should have the presence of Bcellspecific differentiation antigens (CD 19, CD 20, and CD 24) and be CD 5(+) 3) A bone marrow aspirates showing greater than 30% lymphocytes
Investigations n Pretreatment studies of patients with CLL should include examination of: n n n n n complete blood count peripheral blood smear reticulocyte count Coomb’s test renal and liver function tests serum protein electrophoresis immunoglobulin levels plasma 2 microglobulin level If available immunophenotyping should be carried out to confirm the diagnosis Bone marrow biopsy and cytogenetic analysis is not routinely performed in CLL
Staging (1) n Rai Classification for CLL n n n 0 - lymphocytosis (>5 G/L) I - lymphocytosis + lymphadenopathy II - lymphocytosis + splenomegaly +/-lymphadenopathy III - lymphocytosis + anemia (Hb <11 g%) +/lymphadenopathy or splenomegaly IV - lymphocytosis + thrombocytophenia (Plt <100 G/L) +/ - anemia +/-lymphadenopathy +/- splenomegaly
Staging (2) n Binet Classification for CLL n n n A. < 3 involved areas, Hb > 10 g%, Plt > 100 G/L B. > 3 involved areas, Hb > 10 g%, Plt > 100 G/L C. - any number of involved areas, Hb < 10 g%, Plt < 100 G/L
Treatment n Treatment is reserved for patients with low- or intermediate risk disease who are symptomatic or have progressive disease (increasing organomegaly or lymphocyte doubling time of less than 12 months) and patients with high -risk disease n n n Alkylating agents (chlorambucil, cyclophosphamide) Nucleoside analogs (cladribine, fludarabine) Biological response modifiers Monoclonal antibodies Bone marrow transplantation And systemic complications requiring therapy n n antibiotics immunoglobulin steroids blood products
Chronic myelogenous leukemia (CML) is a myeloproliferative disorder characterized by increased proliferation of the granulocytic cell line without the loss of their capacity to differentiate. Consequently, the peripheral blood cell profile shows an increased number of granulocytes and their immature precursors, including occasional blast cells.
Leukemia n Chronic Myelogenous Leukemia n Cancer of the granulocytes or monocytes, compared to leukocytes in lymphocytic leukemia n Comprises about 14% of all adult leukemias n Males slightly higher than females n One of the first cancers to have a specific genetic link to a chromosomal mutation identified for the disease n Philadelphia Chromosome
Pathophysiology n n n Disorder of the stem cells in bone marrow General infection fighting cells are the most harmed > granulocytes and monocytes (aka, neutrophils) These immature cells take over the body’s mature neutrophils and hinder the body’s ability to fight infection properly n n CML is caused by a genetic mutation with chromosomes 9 and 22 in the body Abl on chromosome 9 is translocated to chromosome 22 and fuses with Bcr This ABL-BCR protein is an unregulated tyrosine kinase and thus, is the source of the reproduction of immature granulocytes Other functions include: upstream changes of DNA repair mechanisms, suppression of the body’s programmed cell death proteins, and changes in cytoskeletal structures
HEPATOSPLENOMEGALY
chronic phase accelerated phase
accelerated phase blast crisis
blast crisis
n n A small number of patients show some resistance to Imatanib The BRC-ABL transcript has the ability to mutate and thus make imatinib ineffective Imatinib binds to the closed conformation and BRC-ABL can mutate to the open conformation and thus makes imatanib ineffective Two 2 nd generation TKIs have proven to be more potent and are in trials to determine effectiveness against resistance to imatanib
Treatment Algorithm